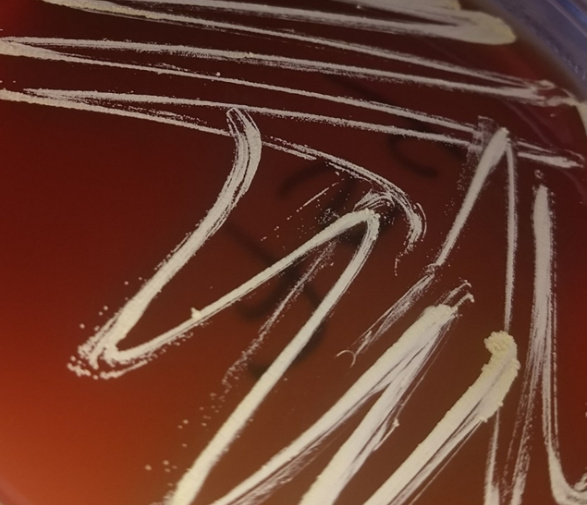
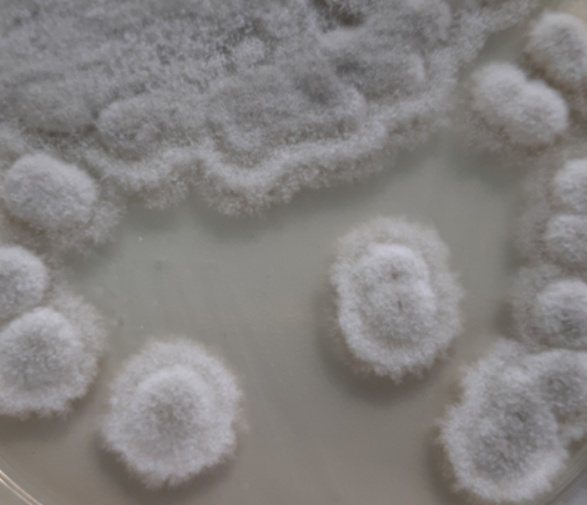

Nocardia cyriacigeorgica (фотографија Оливер Стевановић)
ЈАВНА УСТАНОВА ВЕТЕРИНАРСКИ ИНСТИТУТ РЕПУБЛИКЕ СРПСКЕ “ДР ВАСО БУТОЗАН”
Откриће нових микроорганизама
Током редовних активности на дијагностици и сузбијању маститиса говеда, ЈУ Ветеринарски институт Републике Српске „Др Васо Бутозан“ (ВИРСВБ) суочава се с разним изазовима. Један од њих је идентификација изолованих микроорганизама. У вези с овим важно је напоменути је да су у ВИРСВБ изолована два изузетно ријетка узрочника маститиса крава.
Nocardia cyriacigeorgica, „Бутозан сој“
На двије фарме у Семберији 2022. и 2023. године, изолована је бактеријска врста Nocardia cyriacigeorgica. У питању је патоген човјека који је, до изолације у ВИРСВБ, изолован само у Кини и Бразилу као узрочник маститиса говеда. Урађена је типизација изолата на основу неколико гена, чије су секвенце достављене у генску базу (NCBI), а изолат је окарактерисан као „Бутозан сој“.
Гљивица из рода Scedosporium
Веома ријетка гљивица из рода Scedosporium изолована је почетком 2024. године на фарми говеда у Лопарама. Није позната улога ове гљивице у патогенези маститиса крава, тако да изолација овог узрочника представља изузетно риједак и пионирски налаз у литератури. Даље анализе овог узрочника су у току. Додатне микробиолошке и молекуларне претраге спроводе се у сарадњи са стручњацима из Научног института за ветеринарство „Нови Сад“ из Новог Сада и Факултета ветеринарске медицине Универзитета у Београду.
Култура гљивицe из рода Scedosporium (фотографија Оливер Стевановић)
Контакт
Бања Лука
Aдреса: Бранка Радичевића 18
Контакт
Бијељина
Aдреса: Индустријска зона 2
